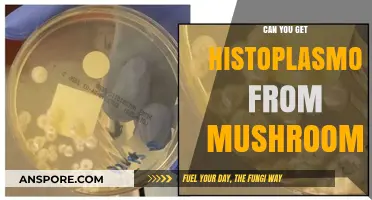
Histoplasmosis and Mushrooms: Unraveling the Connection and Risks Involved

The question of whether you can obtain mushrooms from giant mushrooms is an intriguing one, blending curiosity about fungal biology with practical foraging interests. Giant mushrooms, often referring to species like the iconic *Macrolepiota procera* (Parasol Mushroom) or *Boletus edulis* (Porcini), are indeed capable of producing smaller, edible mushrooms under the right conditions. These larger fungi are typically the fruiting bodies of extensive underground mycelial networks, which can generate multiple mushroom clusters over time. However, harvesting from giant mushrooms requires caution, as not all large fungi are edible, and misidentification can lead to toxicity or poisoning. Understanding the species, its lifecycle, and proper foraging techniques is essential for safely obtaining mushrooms from their giant counterparts.
| Characteristics | Values |
|---|---|
| Source | Giant mushrooms (specific species vary by region) |
| Edibility | Some giant mushrooms are edible (e.g., Macrocybe titans), others are toxic or inedible |
| Common Species | Macrocybe titans (edible), Langermannia gigantea (inedible), Amillaria ostoyae (edible but caution advised) |
| Harvesting | Possible from mature, healthy giant mushrooms |
| Yield | Varies; Macrocybe titans can produce large caps suitable for consumption |
| Habitat | Forests, woodlands, often near tree bases or decaying wood |
| Seasonality | Typically found in late summer to fall, depending on species and climate |
| Precautions | Proper identification is critical; consult experts or guides to avoid toxic species |
| Culinary Use | Edible species can be cooked like regular mushrooms (sautéed, grilled, etc.) |
| Conservation | Harvest sustainably to avoid damaging ecosystems or rare species |
| Myths | Not all giant mushrooms are magical or psychoactive; most are ordinary fungi |
| Research | Limited studies on giant mushroom cultivation; primarily foraged in the wild |
Explore related products
What You'll Learn
- Natural Spawning Conditions: Giant mushrooms may drop spores, allowing smaller mushrooms to grow nearby under right conditions
- Farming Techniques: Players can farm smaller mushrooms by breaking giant ones with specific tools
- Biome Influence: Giant mushrooms often spawn in specific biomes, affecting smaller mushroom growth patterns
- Game Mechanics: Some games allow harvesting smaller mushrooms from giant ones using in-game mechanics
- Real-World Comparison: In nature, large fungi release spores, enabling smaller mushrooms to grow nearby

Natural Spawning Conditions: Giant mushrooms may drop spores, allowing smaller mushrooms to grow nearby under right conditions
Giant mushrooms, often towering and majestic in their presence, are not just static fixtures in their ecosystems. They actively contribute to the growth of new fungal life through the release of spores. These microscopic units of reproduction are akin to seeds in the plant world, dispersed to colonize new areas. When a giant mushroom reaches maturity, it begins to drop spores, a process that can occur in vast quantities, sometimes numbering in the billions per mushroom. This natural mechanism ensures the continuation of the species and fosters biodiversity in the surrounding environment.
The conditions required for these spores to develop into smaller mushrooms are precise and multifaceted. First, the substrate—the material on which the mushrooms grow—must be suitable. This often includes decaying wood, rich soil, or other organic matter that provides the necessary nutrients. Moisture is another critical factor; spores require a consistently damp environment to germinate and grow. Temperature also plays a pivotal role, with most species thriving in cool to moderate climates. For example, the optimal temperature range for many common mushroom species is between 55°F and 70°F (13°C and 21°C). Light exposure, while not always essential, can influence growth patterns, with some species preferring shaded areas.
To encourage the growth of smaller mushrooms from giant ones, consider creating a microenvironment that mimics their natural habitat. Start by collecting spores from a mature giant mushroom using a sterile tool to avoid contamination. Gently place the mushroom cap on a piece of paper or glass for several hours to allow spores to fall. Once collected, mix the spores with a small amount of water to create a spore slurry. Inoculate a prepared substrate, such as a mixture of compost and wood chips, by spraying or pouring the slurry evenly over the surface. Keep the substrate moist by misting it daily and maintain the temperature within the optimal range. Patience is key, as it can take weeks or even months for the first signs of growth to appear.
While this process is natural, it’s important to approach it with caution and respect for the environment. Overharvesting spores or disrupting ecosystems can have unintended consequences. For instance, removing too many spores from a giant mushroom may hinder its ability to reproduce effectively. Additionally, introducing spores to non-native environments can lead to ecological imbalances. Always research the specific needs of the mushroom species you’re working with and adhere to local regulations regarding foraging and cultivation.
In conclusion, giant mushrooms serve as vital contributors to fungal propagation through their spore-dropping mechanism. By understanding and replicating the natural spawning conditions—suitable substrate, moisture, temperature, and light—enthusiasts can foster the growth of smaller mushrooms. This process not only deepens our appreciation for these organisms but also highlights the intricate balance of nature. Whether for scientific study, culinary purposes, or simply the joy of cultivation, the relationship between giant mushrooms and their offspring offers a fascinating glimpse into the resilience and complexity of fungal life.
Growing Oyster Mushrooms on Coffee Grounds: Varieties and Tips
You may want to see also

Farming Techniques: Players can farm smaller mushrooms by breaking giant ones with specific tools
In the world of virtual farming, players often seek efficient ways to gather resources, and mushrooms are no exception. One intriguing method involves harvesting smaller mushrooms from their giant counterparts, a technique that requires precision and the right tools. This approach not only maximizes yield but also adds a layer of strategy to resource management. By understanding the mechanics behind this process, players can optimize their farming efforts and ensure a steady supply of mushrooms for various in-game needs.
To begin, players must identify the specific tools required for breaking giant mushrooms. Axes, pickaxes, or specialized farming tools are often the most effective, depending on the game’s mechanics. For instance, in games like *Minecraft*, a wooden or stone axe can be used, but durability should be monitored to avoid tool breakage mid-task. In contrast, games with more complex systems might require enchanted or upgraded tools to increase efficiency and yield. Always check the game’s tool compatibility guide to ensure you’re using the best equipment for the job.
The process itself is straightforward but demands attention to detail. Approach the giant mushroom and strike it with the chosen tool, ensuring each hit is deliberate to avoid unnecessary damage to the surrounding environment. In some games, the angle and force of the strike can influence the number of smaller mushrooms dropped, so practice makes perfect. For example, in *Stardew Valley*, using a copper axe on a giant mushroom yields 1-3 small mushrooms, but upgrading to an iridium axe increases the drop rate significantly. Timing and tool selection are key to maximizing output.
However, players should be cautious of potential drawbacks. Overharvesting giant mushrooms in certain areas can lead to resource depletion or even alter the ecosystem, affecting other in-game elements. Additionally, some games may impose cooldowns or penalties for excessive farming, so pacing is crucial. A practical tip is to rotate farming locations or allow giant mushrooms time to respawn naturally, ensuring sustainability. This balanced approach not only preserves the game world but also guarantees a long-term supply of mushrooms.
In conclusion, farming smaller mushrooms from giant ones is a viable and rewarding technique for players willing to invest time and strategy. By selecting the right tools, mastering the harvesting process, and practicing sustainability, players can efficiently gather this valuable resource. Whether for crafting, cooking, or selling, this method adds depth to the farming experience and highlights the importance of understanding in-game mechanics to achieve success.
Delicious Recipes Using Canned Cream of Mushroom Soup: Easy Meal Ideas
You may want to see also

Biome Influence: Giant mushrooms often spawn in specific biomes, affecting smaller mushroom growth patterns
Giant mushrooms, often towering structures in certain biomes, play a pivotal role in shaping the growth patterns of smaller mushrooms. These colossal fungi thrive in environments with specific conditions—high humidity, shaded areas, and nutrient-rich soil—typically found in lush forests, swampy regions, or underground caverns. Their presence alters the microclimate, creating pockets of ideal conditions for smaller mushrooms to flourish. For instance, the shade cast by giant mushrooms reduces direct sunlight, while their decaying bases enrich the soil with organic matter, fostering a symbiotic relationship between the two.
To harness this biome influence, consider replicating these conditions in controlled environments. If you’re cultivating mushrooms at home, mimic the shaded, humid conditions of a forest biome by using a grow tent with adjustable humidity levels (aim for 80-90%). Incorporate a substrate rich in organic material, such as composted wood chips or coconut coir, to simulate the nutrient-dense soil found near giant mushrooms. For outdoor cultivation, plant giant mushroom species like *Pleurotus* or *Ganoderma* in shaded, damp areas to create a natural microclimate conducive to smaller mushroom growth.
However, not all biomes support this dynamic. Arid or desert regions, for example, lack the moisture and organic material necessary for giant mushrooms to thrive, thereby limiting their influence on smaller fungi. In such cases, artificial interventions—like misting systems or shade cloths—become essential. Conversely, in biomes like tropical rainforests, where giant mushrooms are abundant, smaller mushrooms often grow in dense clusters around their larger counterparts, forming visible "mushroom rings" that highlight this biome-driven relationship.
A cautionary note: while giant mushrooms can enhance smaller mushroom growth, their presence can also introduce competition for resources. Overcrowding may lead to stunted growth or reduced yields. To mitigate this, space giant mushrooms at least 3-5 feet apart in cultivation setups, allowing smaller mushrooms adequate room to develop. Additionally, monitor pH levels (optimal range: 6.0-6.5) and avoid overwatering, as excess moisture can lead to mold or root rot, undermining the benefits of the biome influence.
In conclusion, understanding the biome-specific influence of giant mushrooms on smaller fungi offers practical insights for both naturalists and cultivators. By recreating the conditions of their native biomes—whether through controlled environments or strategic outdoor placement—you can leverage this relationship to enhance mushroom growth. Whether you’re a hobbyist or a professional, this knowledge transforms giant mushrooms from mere curiosities into powerful tools for fostering thriving fungal ecosystems.
Mushroom Allergies: Symptoms, Risks, and Safe Consumption Tips
You may want to see also
Explore related products

Game Mechanics: Some games allow harvesting smaller mushrooms from giant ones using in-game mechanics
In the realm of video games, the concept of harvesting smaller mushrooms from giant ones is a fascinating mechanic that adds depth to resource gathering and world interaction. Games like *Stardew Valley* and *Minecraft* exemplify this idea, where players can strike large mushroom structures to yield smaller, collectible mushrooms. This mechanic not only encourages exploration but also rewards players for engaging with the environment in meaningful ways. By incorporating such systems, developers create a sense of discovery and accomplishment, making the in-game world feel more alive and interactive.
Analyzing this mechanic reveals its dual purpose: it serves both as a practical resource-gathering tool and a narrative device. In *Super Mario Odyssey*, for instance, giant mushrooms are not just obstacles but also opportunities to collect smaller mushrooms that restore health. This design choice reinforces the game’s emphasis on exploration and problem-solving, as players must decide whether to bypass or engage with these structures. Such mechanics also align with real-world foraging behaviors, where larger fungi often host smaller, edible varieties, bridging the gap between fantasy and realism.
For players looking to maximize this mechanic, understanding timing and tool usage is key. In *Terraria*, using a pickaxe or hammer on a glowing mushroom tree yields more resources than bare hands. Similarly, in *Animal Crossing: New Horizons*, watering giant mushrooms increases the likelihood of smaller mushrooms spawning nearby. These nuances highlight the importance of experimentation and strategy, turning a simple action into a skill-based activity. Players who master these techniques can significantly enhance their in-game efficiency and enjoyment.
Comparing this mechanic across genres reveals its versatility. In survival games like *The Forest*, harvesting mushrooms from giant ones is a matter of sustenance, while in sandbox games like *Minecraft*, it’s part of creative building and farming. This adaptability underscores the mechanic’s appeal—it can be tailored to fit various gameplay styles and objectives. Whether for survival, crafting, or decoration, the act of harvesting smaller mushrooms from giant ones adds a layer of engagement that resonates with diverse player preferences.
In conclusion, the game mechanic of harvesting smaller mushrooms from giant ones is more than a trivial feature—it’s a design choice that enriches gameplay, encourages interaction, and fosters a sense of achievement. By blending practicality with creativity, developers create experiences that are both rewarding and immersive. For players, mastering this mechanic opens up new possibilities, transforming the way they approach in-game environments and resources. Whether you’re a casual gamer or a seasoned veteran, this mechanic offers something uniquely satisfying to explore.
Mushroom Coffee Overdose: Separating Fact from Fiction in Wellness Trends
You may want to see also

Real-World Comparison: In nature, large fungi release spores, enabling smaller mushrooms to grow nearby
In the forest, towering fungi like the honey mushroom (*Armillaria ostoyae*) form vast underground networks, their caps releasing trillions of spores annually. These microscopic units drift on air currents, settling in soil enriched by the parent fungus’s decaying activity. Within days, if conditions align—moisture, temperature, and organic matter—pinhead-sized mycelia sprout, eventually fruiting into smaller mushrooms. This process mirrors how a single mature tree sows seeds, fostering a new generation in its shadow.
To replicate this in cultivation, start by identifying a mature, healthy fungus with visible spore-bearing structures (gills, pores, or teeth). Place a clean container beneath its cap for 24–48 hours to collect spores. Mix the collected spores with sterile water to create a spore slurry, then inoculate pasteurized soil or substrate. Maintain humidity above 85% and temperatures between 68–75°F (20–24°C) for optimal germination. Avoid direct sunlight, as spores require indirect light to develop.
While this method mimics nature, it’s less efficient than using mycelium cultures. Spores are genetically diverse, meaning offspring may vary in traits like size or yield. For consistent results, pair spore collection with tissue culturing: excise a small piece of the parent fungus’s flesh, sterilize it, and grow it on agar. This ensures genetic uniformity, though it demands more technical skill. Both approaches highlight the interconnectedness of fungal life cycles, where giants act as both nurturers and progenitors.
A cautionary note: not all large fungi produce viable spores, and some species’ spores require specific triggers (e.g., fire or frost) to germinate. Always verify the species’ biology before attempting cultivation. For beginners, start with common spore-producers like oyster mushrooms (*Pleurotus ostreatus*), which colonize substrate rapidly and fruit reliably. Advanced growers might experiment with *Amanita muscaria* or *Hericium erinaceus*, whose spores demand precise conditions but yield unique, valuable crops.
Ultimately, observing how giant fungi propagate through spores offers a lesson in sustainability. In nature, this process ensures species survival across generations, while in cultivation, it provides a low-cost, accessible method for mushroom production. By studying these mechanisms, we bridge the gap between wild ecosystems and human innovation, turning forests into both classrooms and laboratories.
Rehydrated Mushrooms: Optimal Storage Tips and Shelf Life Explained
You may want to see also
Frequently asked questions
No, giant mushrooms in the wild, such as those in video games or fantasy settings, are not real and cannot be harvested for edible mushrooms.
No, giant mushrooms in games like Minecraft are fictional and do not correspond to real-life mushroom species that can be harvested.
While some real-life mushrooms can grow very large, "giant mushrooms" as depicted in fiction do not exist. Large fungi in nature do not typically produce smaller edible mushrooms.
No, giant mushrooms are not a real species, so they cannot be cultivated. Edible mushrooms are grown from specific species using proper cultivation techniques.